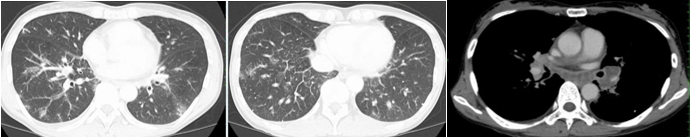

- 2025年10月13日
肺門部リンパ節腫脹の胸部レントゲン写真(X-p):サルコイドーシス、リンパ増殖性疾患、IgG4RD、悪性腫瘍が鑑別
医師は肺門部リンパ節が主張しているかどうかにも当然気を配っています。どのようになると「肺門部リンパ節腫脹」というのでしょうか?その特徴をまとめておきます。
形状の変化:
肺門部が正常時よりも腫れて、輪郭がはっきりしない、または不自然に大きくなったように見えます。
陰影の出現:
炎症や腫瘍などによってリンパ節が大きくなると、X線が透過しにくくなるため、レントゲン写真上では「白い影」として映ります。
片側性または両側性:
リンパ節の腫れは片側だけに現れることもあれば、両側に見られることもあります。

所見としては両側肺門リンパ節腫脹(BHL)、気管分枝部リンパ節腫脹(気管分岐部がもやもやしている)肺紋理の増強が挙げられます。このような場合は、サルコイドーシスやリンパ増殖性疾患、IgG4RDなどを疑い鑑別を進めていきます。
■CT
所見としては気管支壁肥厚と小葉間隔壁の肥厚あり。縦隔条件では肺門部・気管分枝部リンパ節腫脹が確認できます。
気管支鏡生検へ進み、原発不明の腺癌による癌性リンパ管症だった症例です。
柏五味歯科内科リウマチクリニック
ホームページ